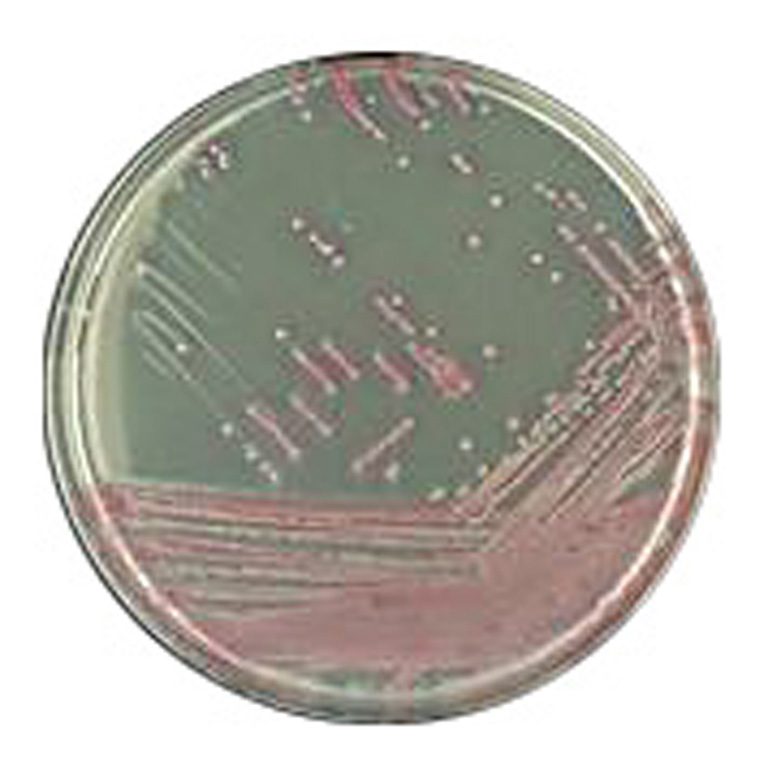

Über das Produkt
Chromogenes Medium zur Isolierung und Differenzierung von Methicillin-resistenten Staphylococcus aureus (MRSA).
CHROMagar MRSA Fertigplatten
Chromogenes Medium zur Isolierung und Differenzierung von Methicillin-resistenten Staphylococcus aureus (MRSA).